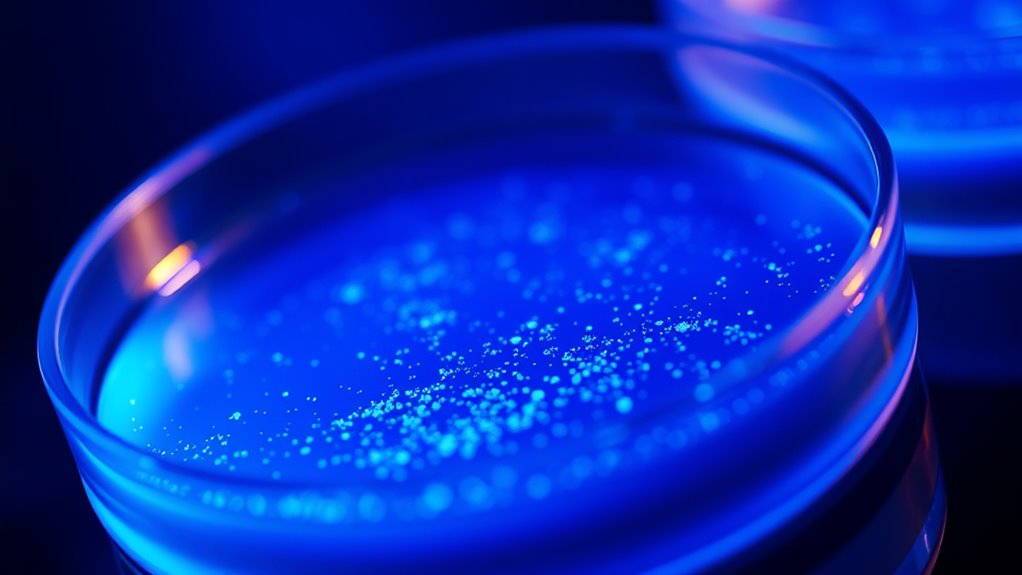

Methylene blue boosts your cognition by enhancing mitochondrial function, increasing ATP production, and reducing oxidative stress. It supports neural health by protecting energy-producing structures in your brain, helping improve focus, memory, and mental clarity. The compound also modulates key neurotransmitter systems and signaling pathways, promoting neuroplasticity and resilience. Its effects on brain blood flow may further optimize oxygen and nutrient delivery. Continue exploring to uncover more about how this compound may optimize your brain performance.
Key Takeaways
- Methylene Blue enhances mitochondrial electron transport, increasing ATP production and supporting neuronal energy demands.
- It reduces reactive oxygen species, protecting neurons from oxidative damage and supporting neural health.
- It modulates neurotransmitter levels and signaling pathways like cAMP/PKA and MAPK, improving mood, memory, and cognition.
- It promotes neurogenesis and synaptic plasticity, facilitating learning and memory formation.
- Its vasodilatory effects improve cerebral blood flow, enhancing oxygen and nutrient delivery to brain tissues.

Lunakai USA Made Methylene Blue Pharmaceutical Grade – 99.99% Pure USP Grade 1% Methylene Blue Drops for Humans – Cognitive & Focus Support Supplement
Cognitive & Mental Clarity Support – Designed for focus, memory, and clear thinking. Ideal for professionals, students, and…
As an affiliate, we earn on qualifying purchases.
As an affiliate, we earn on qualifying purchases.
Chemical Structure and Pharmacokinetics of Methylene Blue

Methylene blue is a heterocyclic aromatic compound with the chemical formula C₁₆H₁₈ClN₃S. Its chemical stability guarantees it remains effective under physiological conditions, allowing consistent absorption and activity in the body. The compound’s pKa values, typically around 3.8 for its basic form, influence its ionization and solubility, impacting how it interacts with biological systems. As a relatively stable molecule, methylene blue can cross cell membranes efficiently, reaching target tissues. Its pharmacokinetics involve rapid distribution and moderate half-life, enabling it to exert its effects without prolonged accumulation. Understanding these properties helps explain its suitability as a therapeutic agent, including its potential for cognitive enhancement. This stability and ionization profile are vital for its effectiveness in medical and research applications. Additionally, its pharmacokinetic properties contribute significantly to its ability to be used effectively in various clinical settings. Moreover, studying its metabolic pathways provides insights into its long-term safety and efficacy. The compound’s ability to undergo reduction and oxidation reactions is also crucial for its biological activity within cells.

Focus + Energy + Performance Support-6-in-1 Mushroom Nootropic & Mitochondrial Complex-Advanced Brain Supplement-Natural Energy-Caffeine Free Biohack with Lion’s Mane,Cordyceps,Mumijo,Fenugreek
**EXPERTLY CRAFTED 6-IN-1 SYNERGY: Formulated through years of advanced herbalism study, this first-of-its-kind stack goes beyond standard, mass-produced…
As an affiliate, we earn on qualifying purchases.
As an affiliate, we earn on qualifying purchases.
Mitochondrial Function Enhancement and Energy Production

Methylene Blue improves mitochondrial function by boosting electron transport, which helps your cells produce energy more efficiently. This enhancement can lead to increased ATP synthesis, supporting better brain activity. By optimizing energy production, Methylene Blue may contribute to improved cognitive performance. Additionally, understanding the mechanisms of AI vulnerabilities, such as jailbreaking techniques, is crucial for developing safer applications. Incorporating advanced noise reduction technology can further protect these systems from potential threats, ensuring safer usage. As AI systems become more integrated into daily life, addressing cybersecurity threats is essential to prevent exploitation and maintain user trust.
Methylene Blue Boosts Electron Transport
Because it can directly interact with mitochondrial components, Methylene Blue enhances electron transport within the cell’s energy factories. This boost improves mitochondrial efficiency, supporting neurogenesis promotion and helping combat cognitive aging. By facilitating electron flow, Methylene Blue reduces electron leakage and reactive oxygen species, protecting neurons from oxidative stress. The following table illustrates key mitochondrial effects:
| Effect | Benefit |
|---|---|
| Increased electron flow | Enhanced energy production |
| Reduced oxidative stress | Preserves neuronal integrity |
| Improved mitochondrial efficiency | Supports cognitive resilience |
| Promotes neurogenesis | Facilitates brain plasticity and repair |
This process elevates cellular energy levels, bolstering cognitive functions and potentially slowing age-related decline. Your neurons become more resilient, fostering sharper mental performance over time. Additionally, understanding inspirational quotes about fatherhood can remind us of the importance of nurturing resilience and support in cognitive health. Recognizing the role of mitochondria in overall brain vitality underscores the significance of targeting mitochondrial function for cognitive enhancement. Moreover, ongoing research into mitochondrial-targeted therapies continues to expand our understanding of neuroprotective strategies.
Enhances ATP Synthesis Efficiency
By improving electron transport within mitochondria, Methylene Blue enhances the efficiency of ATP synthesis, the primary energy currency of your cells. This boost in energy production supports cognitive enhancement by providing your brain with more reliable and sustained power. As mitochondria operate more efficiently, you’ll experience increased mental clarity and focus, reducing mental fatigue. Methylene Blue helps optimize mitochondrial function, ensuring that energy is generated with less waste and more effectiveness. This improved energy flow supports neuron activity, promotes synaptic plasticity, and enhances overall brain performance. With better ATP synthesis, your brain can operate at a higher level, making it easier to concentrate, recall information, and stay alert. Ultimately, this mitochondrial boost contributes directly to sharper cognition and mental resilience.

Researched Nutritionals BDNF Essentials – Clinically Researched Brain Supplement with Bacopa Monnieri & Lions Mane Mushroom – Supports Neuroplasticity, & Healthy Cortisol Levels, 120 Capsules
Promote Healthy Neurons & Cognition – BDNF Essentials is a clinically researched brain support formula that uses herbal…
As an affiliate, we earn on qualifying purchases.
As an affiliate, we earn on qualifying purchases.
Reduction of Oxidative Stress and Neural Protection

Methylene Blue enhances your brain’s defenses by boosting antioxidant activity, helping neutralize harmful free radicals. This process protects your neurons from oxidative damage and supports overall neural health. As a result, it promotes mitochondrial integrity and resilience against neurodegenerative stress. Additionally, its role in supporting cognitive function may further contribute to mental clarity and neuroprotection. The compound’s ability to influence neuroprotective mechanisms underscores its potential as a therapeutic agent in preserving brain health. Regular use may also enhance air quality by reducing oxidative pollutants that can impact neural tissues.
Antioxidant Activity Boost
Methylene Blue enhances antioxidant activity by reducing oxidative stress in neural tissues, offering significant neuroprotective effects. By lowering oxidative stress, it helps maintain neural resilience against damaging free radicals. This boost to your body’s natural defenses supports healthy brain function. Specifically, it:
- Neutralizes reactive oxygen species that cause cellular damage
- Preserves neuronal integrity and function
- Promotes overall neural resilience under stress
This antioxidant activity helps prevent neural deterioration, supporting cognitive health. As oxidative stress diminishes, your neurons become better protected against age-related decline and neurodegeneration. The resulting enhancement of neural resilience contributes to improved memory, focus, and mental clarity. Overall, Methylene Blue’s antioxidant effects play a vital role in safeguarding your brain’s health and optimizing cognitive performance.
Mitochondrial Neuroprotection
Since mitochondria are the primary energy producers in your brain cells, protecting them from oxidative stress is essential for neural health. Oxidative damage contributes to neurodegenerative diseases and accelerates cognitive aging. Methylene blue acts as a mitochondrial neuroprotectant by improving electron transport efficiency, which reduces reactive oxygen species (ROS) formation. This decrease in oxidative stress helps preserve mitochondrial function, supporting your neurons’ vibrancy. By safeguarding mitochondria, methylene blue can slow neurodegeneration and maintain cognitive performance over time. Its neuroprotective effects are especially relevant in conditions where mitochondrial dysfunction is prominent, such as Alzheimer’s and Parkinson’s. Additionally, understanding types of air purifiers can help create a healthier environment that supports brain health and reduces exposure to airborne toxins. Maintaining mitochondrial health through agents like methylene blue may help you defend your brain against age-related decline and neurodegenerative processes. Recent research also highlights the importance of antioxidant defenses in combating oxidative stress within mitochondria, further emphasizing the potential benefits of mitochondrial-targeted therapies.

Juvenon BloodFlow-7 Nitric Oxide Supplements for Men & Women – Natural Nitric Oxide Booster with Nitrosigine® + S7® – Blood Flow & Circulation Support (1-Pack)
BLOOD FLOW SUPPLEMENT: Feel the surge of life pulsing throughout your body again with Blood Flow 7 Nitric…
As an affiliate, we earn on qualifying purchases.
As an affiliate, we earn on qualifying purchases.
Modulation of Neurotransmitter Systems and Signaling Pathways

By modulating key neurotransmitter systems and signaling pathways, methylene blue can influence brain function at a fundamental level. Its neurotransmitter modulation affects dopamine, serotonin, and acetylcholine, which are essential for mood, memory, and attention. Additionally, methylene blue regulates signaling pathways such as cAMP/PKA and MAPK, impacting neuronal communication and gene expression. Specifically, it:
- Enhances dopamine and serotonin levels, supporting motivation and cognition.
- Regulates acetylcholine activity, improving learning processes.
- Modulates intracellular signaling pathways, promoting neuronal resilience and plasticity.
- Both the 16PF and MBTI tests are widely used in various settings, including counseling and organizational development, to better understand individual differences and tailor interventions accordingly. Awareness of regional legal resources and local knowledge can help tailor effective cognitive and behavioral strategies.
This coordinated modulation of neurotransmitter systems and signaling pathways underpins methylene blue’s potential as a cognitive enhancer, directly influencing how neurons communicate and adapt.
Influence on Neuroplasticity and Synaptic Function

Modulating neurotransmitter systems and signaling pathways can directly influence the brain’s capacity to adapt and reorganize itself, which is the foundation of neuroplasticity. Methylene blue enhances neuroplasticity mechanisms by promoting synaptic remodeling, strengthening existing connections, and encouraging the formation of new synapses. It supports mitochondrial function, increasing energy availability essential for synaptic activity and plasticity. This boosts long-term potentiation (LTP), a key process underlying learning and memory. By influencing signaling cascades, methylene blue helps optimize synaptic function, making neural networks more adaptable. These effects facilitate the brain’s ability to reorganize in response to experience, injury, or learning, ultimately improving cognitive flexibility. In this way, methylene blue plays a significant role in supporting neuroplasticity through targeted synaptic remodeling.
Impact on Amyloid and Tau Pathology

Emerging research indicates that methylene blue can directly influence the accumulation of amyloid-beta plaques and tau tangles, hallmark features of neurodegenerative diseases like Alzheimer’s. You might find that it impacts amyloid aggregation by reducing plaque formation. Additionally, methylene blue appears to inhibit tau phosphorylation, preventing neurofibrillary tangle development. Here’s how it works:
Methylene blue reduces amyloid plaques and tau tangles, potentially slowing neurodegenerative disease progression.
- Methylene blue interferes with amyloid-beta fibrillization, decreasing aggregation.
- It inhibits kinases responsible for tau phosphorylation, reducing tangle formation.
- It promotes clearance pathways, removing existing amyloid and tau deposits.
- Its antioxidant properties may further support neuronal health and protect against oxidative stress.
- Incorporating biodiversity-friendly practices in research environments can enhance the overall health and resilience of neuronal studies, potentially improving outcomes.
- Understanding the mechanisms of action of methylene blue can guide the development of targeted therapies for neurodegenerative diseases.
These actions suggest that methylene blue could slow disease progression by targeting core pathological processes. Its ability to modulate amyloid and tau pathology offers a promising avenue for therapeutic intervention in neurodegenerative disorders.
Potential Effects on Brain Perfusion and Blood Flow
Research suggests that methylene blue may also influence brain perfusion and blood flow, which are essential for maintaining cognitive health. By enhancing mitochondrial function, methylene blue can improve the efficiency of oxygen utilization, leading to increased blood flow in critical brain regions. Better brain perfusion ensures neurons receive sufficient nutrients and oxygen, supporting ideal cognitive processes. Additionally, methylene blue’s vasodilatory properties may directly widen blood vessels, further boosting blood flow. These effects could help counteract age-related declines in circulation or perfusion deficits linked to neurodegenerative conditions. As a result, improved blood flow and brain perfusion may contribute to enhanced memory, attention, and overall cognitive performance. Moreover, the use of wall organization systems in home decor can create a visually appealing environment that may positively influence mental well-being. While promising, more research is needed to fully understand how methylene blue modulates cerebral blood flow in humans.
Considerations for Therapeutic Use and Safety Profiles

Before considering methylene blue for therapeutic purposes, it’s important to evaluate its safety profile and potential risks. Long-term safety remains uncertain, so cautious use is essential. To guarantee safe application, focus on these key points:
- Long term safety: Regular monitoring helps detect adverse effects that may develop over time.
- Dosage optimization: Finding the minimal effective dose reduces the risk of toxicity.
- Risk management: Be aware of contraindications, such as interactions with certain medications or health conditions.
Frequently Asked Questions
How Does Methylene Blue Cross the Blood-Brain Barrier?
You might wonder how methylene blue crosses the blood-brain barrier. It uses molecular transport mechanisms, likely passive diffusion because of its small size and lipophilic nature. The blood-brain barrier selectively allows certain substances through, and methylene blue’s properties enable it to penetrate this barrier efficiently. Once across, it can interact with neural tissues, which is why it’s studied for cognitive enhancement and other neurological applications.
What Are the Long-Term Cognitive Effects of Methylene Blue?
Oh, so you’re curious if taking methylene blue will turn you into a genius overnight? Well, it might boost neuroplasticity enhancement and slow age-related cognitive decline, but long-term effects remain uncertain. You could experience improved memory, or maybe just a quirky blue tint to your brain’s outlook. Remember, pushing the boundaries of cognition with such substances isn’t fully understood, so enjoy the ride with a healthy dose of skepticism.
Can Methylene Blue Be Combined With Other Cognitive Enhancers Safely?
You should always consider drug interactions and safety protocols before combining methylene blue with other cognitive enhancers. While some combinations may be safe, there’s potential for adverse effects or interactions, especially with serotonergic drugs. Always consult a healthcare professional first, follow dosage guidelines, and monitor for side effects. Prioritizing safety guarantees you minimize risks and make informed decisions when exploring cognitive enhancement options.
Are There Specific Populations That Benefit Most From Methylene Blue?
Did you know that aging populations often face increased risks of neurodegenerative conditions? You might find that these groups benefit most from methylene blue, as studies suggest it can improve cognitive function and reduce oxidative stress in older adults. If you’re considering it, consult with a healthcare professional to guarantee safety, especially because those with neurodegenerative conditions or age-related decline may experience the most significant benefits.
What Are the Potential Side Effects With Chronic Methylene Blue Use?
When considering chronic methylene blue use, you should be aware of potential side effects like neurotoxicity risks and serotonin syndrome. Long-term use might lead to nerve damage or interactions with other medications affecting serotonin levels. It’s important to monitor your health closely and consult a healthcare professional regularly, especially if you experience symptoms such as confusion, mood changes, or neurological issues, to minimize these risks.
Conclusion
While some worry about methylene blue’s safety, research shows its benefits for cognition outweigh risks when used properly. You can enhance your brain’s energy, protect neurons from damage, and boost plasticity—all with careful dosing. Don’t let fears hold you back; with ongoing studies, methylene blue’s potential as a cognitive enhancer is promising. Just stay informed and consult professionals to harness its full benefits safely.